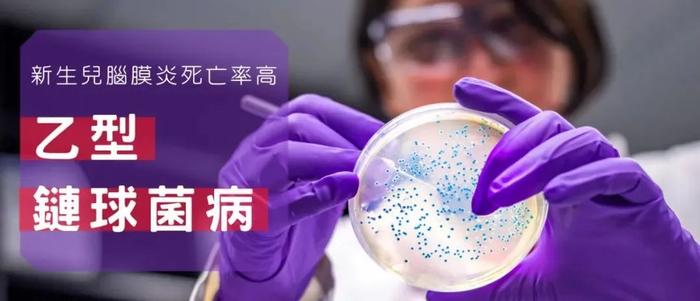

原标题:致命病菌同归“鱼”尽?40天79人感染7人死亡!处理这种鱼要加倍小心 来源:上观新闻
香港卫生防护中心10月18日公布,过去40天接获医院管理局通报,有79名患者感染侵入性乙型链球菌住院,较过去3年有大幅增长。79例感染病例中有7人死亡,38人留院治疗,34人出院。

“放倒”他们的是这种致命病菌
香港卫生防护中心早前公布,今年9月至10月10日期间,共有79例侵入性乙型链球菌感染病例,涉及42男、37女,年龄在1个月至96岁之间,他们主要出现败血症、脑膜炎、化脓性关节炎或脓肿/蜂窝组织炎等。

感染及传染病科专科医生表示,侵入性乙型链球菌是常见的细菌,但鲜有暴发出现,患者通常是个别的怀孕妇女或初生婴儿,如怀孕初期于泌尿系统发现侵入性乙型链球菌,医生就会开抗生素处方,降低对胎儿的影响。

新加坡也曾“爆雷”
联合国联农组织发出警告
过去3年,入侵性乙型链球菌感染病例平均每月只有9-26宗。而这次短时间内集中爆发,可能与处理、进食淡水鱼有关。

据香港防护中心调查取样,发现大多数感染者是厨师和兼职鱼贩,他们发病前,都曾接触过淡水鱼,如鲩鱼。有的曾经吃过,有的说自己煮鱼时手上带有伤口。
而且,检测发现近一半患者,都感染了st283乙型链球菌。这种型号的病菌,喜欢寄生于活鱼体内。一旦人吃了没有经过任何杀菌处理的鱼类,它就会立刻找到下一任宿主,且大面积扩散前,宿主不会察觉。

其实,这次香港出现的乙型链球菌并非世界首次发现。早在2015年,新加坡国家环境局就已公布。
在新加坡当时的355例感染病例中,有150人被怀疑是因进食生鱼片而感染,其中2人死亡,有人截肢保命。

当年12月5日,新加坡宣布无限期禁止商贩、自助餐供货商等零售商售卖淡水鱼生鱼片,违者可被勒令停业。

目前,老挝、泰国、越南等东南亚国家也发现了乙型链球菌入侵感染病例。其中,侵入性st283乙型链球菌在泰国和老挝,感染人的比例更是高达70%。而且,超20%的感染病例为健康的成年人,没有合并症。
联合国联农组织由此发出警告,提示小心食用在东南亚地区广泛食用的淡水鱼——罗非鱼。此外,广东养殖的虎纹蛙亦曾分离出乙型链球菌的st283的变异型株。
侵入性乙型链球菌一旦入血,就能破坏人体不同器官,导致败血症、脑膜炎等,严重可致死。

但一开始,它却会很“温柔”,以st283乙型链球菌为例,初期人只感觉有点发烧、身体不适,并没有特别剧烈的表现;等到后期,人的颈椎、脊椎、关节、脚踝等位置,都有可能被入侵,造成严重感染,甚至骨骼坏死截肢或死亡。
对于健康的人,这种细菌同样狠——可造成人脑损伤等。如果长期寄生在孕妇身上,它可能还会诱发宝宝脑膜炎。
处理海鲜时要戴手套
还要煮熟再吃
为了免受乙型链球菌拖累,专家建议,大家要避免徒手拣鱼,处理海鲜鱼虾时要戴手套。此外,手部有伤口、有免疫力问题或有长期患病的人要格外小心。最后还要记得,海鲜鱼虾要彻底煮熟才能下肚。

最近这段时间,宁可煮熟一点,还是要安全第一!

投稿:shmfrmt@163.com
(注:稿件标题+作者姓名+图文或视频等)
上观号作者:上海民防

